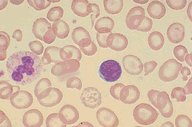

Description
This low oil view of a patient with alpha thalassemia-hemoglobin
H disease shows significant hypochromia and microcytosis. A few
target cells are also seen.
|
|
Click on this image
to enlarge it, then
on Back buttom
in the Netscape Menu
to shrink it back down



|